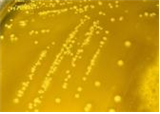

(세균) Yersinia pseudotuberculosis
-
- 작성자
- 최고관리자
-
- 조회
- 1,318
-
- 작성일
- 2020-02-10
(세균) Yersinia pseudotuberculosis
출처:http://phil.cdc.gov/phil/details.asp ID#17254,CDC/ Dr. Todd Parker. Ph.D.;Assoc.Director for Lab. Science/DPEI (Acting) and LRN Training Coordinator
• 위 험 군 :제 2위험군
• 국내범주 :-
• 특 성 :Enterobactericeae과, 그람음성, 막대균, 포자형성 안함, 실온에서는 운동성이 있으나 37℃에서는 운동성 없음, 조건무산소성
병원성 및 감염증상
- 잠복기 : 5~10일, 최대 21일
- 장간막 림프절염(mesenteric lymphadenitis), 위장염 등 급성 장관 질환을 유발함.
- 감염 시 복통, 열이 있으며, 설사증상이 나타나기도 함. 1~3주 후 반응성 관절염(reactive arthritis), 결절성 홍반(erythema nodosum) 등의 합병증이 나타날 수 있음.
- 어린이, 청년에서 흔히 발생하며, 면역저하자에서 심각한 질병을 유발하거나 사망률이 높음.
치료 및 백신
- 치료 : ampicillin, 3세대 cephalosporins, aminoglycosides, tetracyclines, chlorampenicol에 감수성 있음.
- 백신 : -
실험실 생물안전정보
- 감염위해요소
- 감염 경로
- 일반 감염경로:분변-경구 경로로 동물에서 사람, 사람 간 전파가 가능함. 오염된 음식 섭취, 오염된 토양에 접촉할 경우 감염됨. 국내에서는 약수를 마시고 감염된 사례가 있음.
- 실험자 감염경로: 우발적 접종, 섭취로 인하여 감염 가능함. - 감염량 : 경구로 108 개
- 숙주:주로 쥐 등의 야생 포유류, 돼지, 소, 애완동물, 야생조류, 사람은 우연숙주 (incidental host)
- 실험실 획득감염: -
- 생물안전밀폐등급
- BL2 권장: 임상검체, 의심검체, 감염성물질, 배양체를 취급하는 실험
- ABL2 권장:동물 감염실험 및 감염동물 해부 등
- 개인보호장비 : 반드시 실험복을 착용하고, 감염성물질이 피부에 직접적으로 접촉할 경우 장갑 착용, 감염성물질이 튈 우려가 있을 경우 눈보호구 착용, 에어로졸 발생우려가 있는 조작과 대량 또는 고농도의 균 취급 시 생물안전작업대(BSC) 내에서 작업할 것을 권장. 날카로운 도구 사용 제한.
- 소독 및 불활성화 : 1% sodium hypochlorite, 70% ethanol, 2% glutaraldehyde, 2% peracetic acid, 3~6% hydrogen peroxide, 0.16% iodine, 2~5% phenol, 121℃에서 12분 이상 고압증기멸균, 170℃에서 1시간 이상 건열멸균 등
- 숙주 외 환경저항성:강물에서 15일까지, 6~8℃의 바닷물에서 3~4일간, 토양에서 9개월까지 생존 가능함
- 폐기물 처리:감염성물질을 취급한 모든 폐기물은 고압증기멸균 등의 처리 후 의료폐기물로 처리
